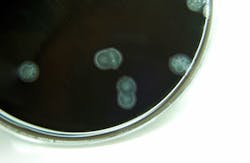
Campylobacter bacteria Campylobacter bacteria
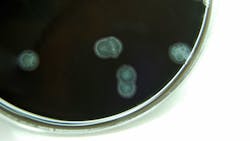
Ts 121883761 720x405 72dpi Rgb Ts 121883761 720x405 72dpi Rgb

The U.S. Centers for Disease Control and Prevention (CDC) has released a new report revealing that the number of some foodborne illnesses was on the rise last year, while others remained unchanged.
The Foodborne Diseases Active Surveillance Network (FoodNet) report said that in comparison to a base period between 2006 and 2008, there was a 14 percent increase in the incidence of infections caused by campylobacter — bacteria linked to many food products, including raw milk, poultry and produce. Rates of infection reached their highest level since 2000, with more than 14 people in every 100,000 affected, the CDC noted. Campylobacter usually causes fever, stomach pain and diarrhea.
Rates of infection caused by vibrio pathogens, typically linked to raw shellfish, increased by 43 percent from 2006-2008 but still remain relatively low compared to other foodborne diseases, affecting 0.41 people out of 100,000. The disease caused by vibrio can be particularly dangerous to people with liver disease. The good news is that the most serious strain of the bacteria, vibrio vulnificus, has not changed, the report found.
According to CDC director Tom Frieden, U.S. consumers benefit from one of the safest food supplies in the world. Still, he acknowledged that certain foodborne diseases were a serious challenge. Even though modern technology provides the industry with the tools to detect an outbreak faster than ever before and to implement measures that restrict the infection and protect people from having access to contaminated products, there are still infections whose rates of incidence are increasing, he pointed out.
RELATED: Salmonella outbreak from cucumbers affects people in 18 states
Technology that Frieden mentioned has helped the industry make notable progress in keeping infection rates from a Shiga toxin-producing E. coli (STEC) O157 down over the past few years, but 2012 saw a slight increase again. According to the CDC report, incidence of STEC O157 infection dropped to 0.95 per 100,000 population in 2010, but last year went back up to 1.12 per 100,000 population.
In 2012 a total of 19,531 foodborne illnesses were reported, with 4,563 people hospitalized for treatment and 68 deaths caused by nine different germs found in food products. The FoodNet project is a joint effort of the CDC, the U.S. Department of Agriculture's Food Safety and Inspection Service (FSIS), the U.S. Food and Drug Administration (FDA) and ten state health departments. It aims to keep track of the incidence of a selected group of infections, the CDC explained.
The CDC advises consumers to assume that raw chicken and other meat carries bacteria and make sure that these foods do not cross-contaminate surfaces and other foods while being handled. People should also ensure that meat is properly cooked, including seafood, and avoid consuming raw milk and unpasteurized soft cheeses. People at greater risk of foodborne illness with the most severe outcomes, such as pregnant women and those with weakened immune systems, are advised not to eat raw or partially cooked seafood at all, including oysters.